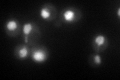
YDR363W-A
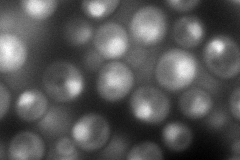
YDR363W-A
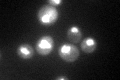
YDR363W-A

View description
Component of the lid subcomplex of the regulatory subunit of the 26S proteasome; involved in mRNA export mediated by the TREX-2 complex (Sac3p-Thp1p); ortholog of human DSS1
Localization:
Intensity:
Fold change:
Significance:
-
C’ GFP library in SD
nucleus115.05 -
N' NOP1pr-GFP in SD
punctate,nucleus208.619 -
N' TEF2pr-mCherry in SD

nucleus439.935 -
N' NATIVEpr-GFP in SD

punctate,nucleus122.27 -
N' TEF2pr-VC and Cyto-VN in SD

#N/A0 -
C’ GFP library in SD+DTT

nucleus151.361.31No -
C’ GFP library in SD+H2O2

nucleus91.590.79No -
C’ GFP library in Starvation Media
nucleus154.271.34No -
C’ GFP library on the background of Pup2-DaMP

nucleus -
C’ GFP library on the background of CCT mutant

nucleus102.810.893549No
